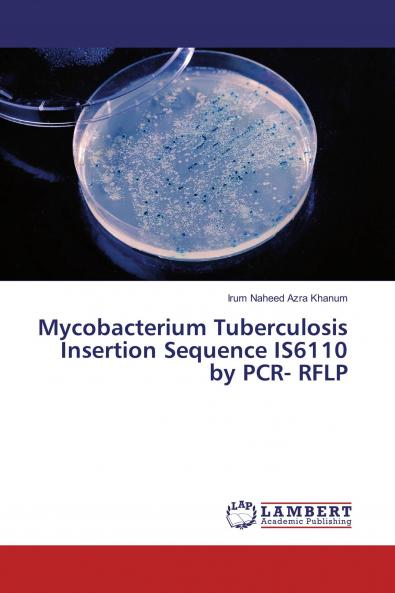
Mycobacterium Tuberculosis Insertion Sequence IS6110 by PCR- RFLP

English
Paperback
₹3775
(All inclusive*)
Delivery Options
Please enter pincode to check delivery time.
*COD & Shipping Charges may apply on certain items.
Review final details at checkout.
Looking to place a bulk order? SUBMIT DETAILS
Delivery Options
Please enter pincode to check delivery time.
*COD & Shipping Charges may apply on certain items.
Review final details at checkout.
About The Book
Description
Author
Tuberculosis (TB) is the foremost reason of death in the world caused by Mycobacterium tuberculosis (M. tb). According to WHO TB kills 5000 people a day and approximately three million people annually. The prevalence rate of TB has been increasing day by day in Pakistan. Emergence of MDR strains of M. tb is of great epidemiological concern. Resistance of M. tb to antibiotics is due to mutations in certain genes. In this study mutations associated with ethambutol (EMB) resistance were determined through RFLP analysis. Alterations in codon positions 306 and 497 of embB gene were screened. IS6110 is an insertion element which is exclusively found within the member of M. tuberculosis complex (MTBC) and it acts as an important diagnostic tool in the identification of these species. The DNA was extracted from M. tb culture and subjected to digestion by restriction enzyme PvuII. Then RFLPs pattern were studied by using Southern blotting to check diversity. The copy number of IS6110 vary in these isolates. Isolates of M. tb from closely related areas show more similarities as compared to isolates of distant areas.
Details
ISBN 13
9783659878305
Publication Date
-02-08-2016
Pages
-68
Weight
-101 grams
Dimensions
-150x220x4.09 mm